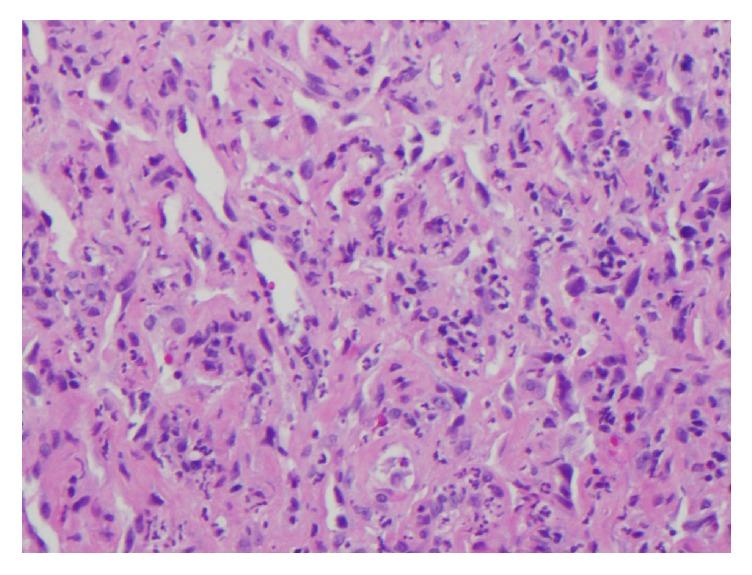
https://cdn.ncbi.nlm.nih.gov/pmc/blobs/8f77/6032971/13e72686b37e/CRIDM2018-8409820.003.jpg

广泛头皮皮肤血管肉瘤
Extensive Cutaneous Scalp Angiosarcoma.
作者信息
Bhatti Zabeer, Bhatti Rameez, Brangman Sharon, Whiting Kerry, Dhamoon Amit
机构信息
State University of New York Upstate Medical University, 750 E. Adams Street Syracuse, NY 13210, USA.
Avalon University School of Medicine, 122-124 Santa Rosaweg, Curacao, Netherlands.
出版信息
Case Rep Dermatol Med. 2018 Jun 21;2018:8409820. doi: 10.1155/2018/8409820. eCollection 2018.
Angiosarcoma is a cancer that is derived from endothelial cells that line blood vessels and lymphatic channels. Cutaneous angiosarcoma can appear anywhere on the skin and the clinical presentation is highly variable. Most cases appear on the scalp and face de novo. Our case describes a 91-year-old female with cutaneous scalp angiosarcoma. Our case serves to remind physicians that an abnormal skin finding in older adults should raise their index of suspicion for angiosarcoma and an early biopsy should be performed.
血管肉瘤是一种起源于血管和淋巴管内衬内皮细胞的癌症。皮肤血管肉瘤可出现在皮肤上的任何部位,临床表现高度多变。大多数病例最初出现在头皮和面部。我们的病例描述了一位91岁患有头皮皮肤血管肉瘤的女性。我们的病例旨在提醒医生,老年人皮肤出现异常表现时应提高对血管肉瘤的怀疑指数,并应尽早进行活检。